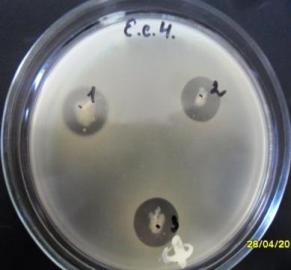

Ветеринария/1.Ветеринарная медицина
Капустина О.А., Гаранкина
А.Ю.,
д.б.н. Карташова О.Л.,
д.в.н. Жуков А.П.
Оренбургский государственный
аграрный университет, Россия
Изучение антагонистической
активности микроорганизмов, входящих в
состав ветеринарных пробиотиков, в отношении
условно-патогенных микроорганизмов
Пробиотики не только
являются предметом всесторонних научных изысканий, но и представляют собой
важный товар на мировом рынке. На сегодняшний день широкому кругу потребителей
доступны сотни пробиотических продуктов питания и пищевых добавок,
производители которых обещают решение самых разнообразных проблем со здоровьем.
Однако доступные пробиотики зачастую характеризуются низким качеством [2].
Микроорганизм, указанный в составе препарата, может отсутствовать в продукте,
либо присутствовать в небольшом количестве, не всегда обладает заявленным
спектром антагонистической активности. В результате снижается эффективность
препарата, что вызывает нарекания со стороны специалистов [1]. Эти факторы
усложняют выбор наиболее эффективного пробиотика для лечения заболеваний
желудочно-кишечного тракта. Актуальным является исследование, направленное на
изучение антагонистической активности
микроорганизмов, входящих в состав ветеринарных пробиотиков, как одной из наиболее
важных биологических характеристик данных штаммов.
В связи с этим целью нашей работы явилось исследование
антагонистической активности штаммов, входящих в состав ветеринарных
пробиотиков, в отношении условно-патогенных микроорганизмов.
Материалы
и методы. Материалом исследования послужили 24 штамма
условно-патогенных микроорганизмов: гемолитическая E. сoli (6 штаммов), грибы
рода Candida (6 штаммов), бактерии
рода Staphylococcus (6 штаммов) и Kledsiella (6
штаммов), предоставленные лабораторией по изучению механизмов персистенции
микроорганизмов ИКВС УрО РАН, 3 штамма бактерий рода Lactobacillus sp., выделенных из ветеринарных пробиотиков Лактоферон,
Лактоамиловорин и Лактобифадол, 3 штамма E.
сoli, выделенных из пробиотиков Микроцикол,
Колибактерин, Бификол.
Выделение и идентификацию микроорганизмов проводили общепринятыми
методами на основании морфологических, тинкториальных, культуральных и
биохимических свойств [6]. Антагонистическую активность пробиотических штаммов изучали модифицированным
вариантом чашечного метода выявления отсроченного антагонизма по Frederiq [4] и методом прямого антагонизма [3].
Статистическую обработку
проводили с использованием параметрических методов. Достоверность различий
оценивали по критерию Стъюдента [5].
Результаты. В ходе исследования на основании
морфологических, тинкториальных, культуральных и биохимических свойств было
выявлено, что штаммы, выделенные из пробиотиков Лактобифадол и Лактоферон
относятся к виду L. аcidophilus, из препарата Лактоамиловорин
- L. аmylovorum, из Микроцикола, Колибактерина и Бификола - E.
сoli.
При изучении антагонистической
активности методом отсроченного антагонизма было
выявлено, что все три пробиотических штамма E.coli проявили антагонистическую
активность только в отношении условно-патогенных E.coli со средним значением
коэффициента антагонистической активности: 2,1±0,26 для Микроцикола, 1,1±0,18
для Колибактерина и 1,12±0,22 для Бификола. В отношении Klebsiella spp.
проявил антагонизм только штамм E.coli, выделенный
из Микроцикола со средним значением
коэффициента 1,7± 0,35 (рис. 1). Антагонистической активности в отношении
Staphylococcus spp. и грибов рода Candida выявлено не было.
При изучении
антагонистической активности пробиотических штаммов лактобацилл в отношении
условно-патогенных микроорганизмов методом отсроченного антагонизма ни к одному
штамму условно-патогенных микроорганизмов
явления антагонизма выявлено не было.

А Б
Рис. 1. Антагонистическая активность
пробиотических
штаммов E. coli в отношении: А- E. coli; Б- Klebsiella spp.
Антагонистическая
активность пробиотических штаммов бактерий рода Lactobacillus sp. была выявлена только при
использовании метода прямого антагонизма. Так, наиболее выраженный антагонизм
проявили штаммы лактобацилл, выделенных из Лактобифадола и Лактоферона в
отношении бактерий рода Staphylococcus sp.,
снижая численность последних практически до 0 КОЕ/мл. Штамм L. аcidophilus,
выделенный из Лактобифадола, снижал численность бактерий рода Klebsiella sp. с 2,8±0,001 *105 до
1,14±0,297 *105 КОЕ/мл, грибов рода Candida sp. с 3,18±0,019 *105 до
1,36±0,081 *105 КОЕ/мл и Е. coli
с 3,18±0,034 *105 до 1,34±0,238 *105 КОЕ/мл. Штамм
L. аcidophilus,
выделенный из Лактоферона, снижал численность грибов рода Candida sp. и Е. coli в 6 и 4,5 раза соответственно (до 0,6±0,16 *105 и
0,7±0,09 *105 КОЕ/мл), у бактерий рода Klebsiella sp. - в 1,5 раза (1,8±0,22*105
КОЕ/мл).
![]()

Рис. 2 Антагонистическая
активность пробиотических штаммов бактерий рода Lactobacillus в отношении и условно-патогенных микроорганизмов
(*р < 0,01; ** р < 0,05)
Штамм L. аmylovorum, выделенный из Лактоамиловорина, снижал численность бактерий рода Staphylococcus sp. в 4,7 раза (с 4,24±0,43
*105 до 0,90±0,020 *105 КОЕ/мл), Klebsiella sp. - в 2,8 раза (1,07±0,295
*105 КОЕ/мл), Candida sp. - в 1,6 раза (2,03±0,138
*105 КОЕ/мл). На численность Е.
coli штамм L. аmylovorum влияния не оказывал (рис.2).
Условно-патогенные
микроорганизмы, в свою очередь, на численность пробиотических лактобацилл
влияния не оказывали.
Выводы.
1.
Метод
прямого антагонизма имеет качественные преимущества при оценке антагонистической
активности Lactobacillus в отношении
условно-патогенных микроорганизмов по сравнению с методом отсроченного
антагонизма.
2.
Пробиотические штаммы E.coli антагонистически активны в отношении условно-патогенных E.coli.
3.
Максимальная
антагонистическая активность пробиотических Lactobacillus
sp. отмечена в отношении бактерий
рода Staphylococcus.
4.
Выявлено,
что L. аcidophilus проявляют большую антагонистическую
активность в сравнении с L. аmylovorum.
Литература:
3. Ермоленко, Е.И.
Взаимодействие С. albicans и Lactobacillus plantrum in
vitro / Е.И.
Ермоленко, С.Х. Ждан-Пушкина, А.Н. Суворов // Проблемы медицинской микологии. -
2004. - Т.6. - №2. - С. 49-54.
4. Кудлай, Д.Г.
Бактериоциногения / Д.Г. Кудлай, В.Г. Лихо дед. - М.:
Медицина, 1966. - 203 с.
5. Лакин, Г.Ф. Биометрия /
Г.Ф. Лакин. - М.: Высш. школа, 1980. - 293 с.
6. Определитель бактерий
Берджи.- М.: Мир,1997-432с.